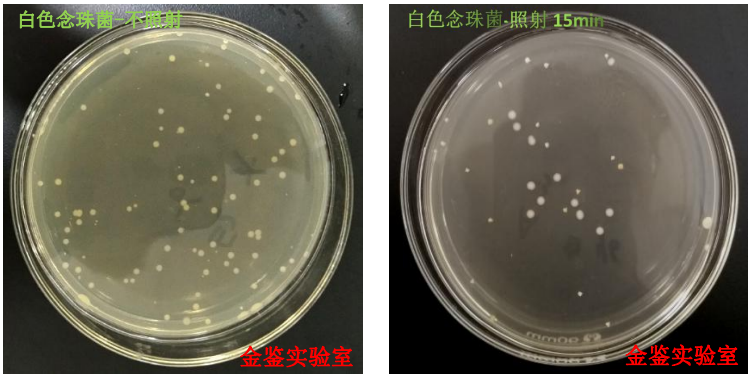
3.png

根据2020年1月28日,国家卫健委和国家中医药管理局公布的
《新型冠状病毒感染的肺炎诊疗方案(试行)第四版》描述:
病毒对紫外线和热敏感。也就是说:紫外线能杀死新型冠状病毒
(2019-nCoV)。随着紫外线LED的功率提升与技术精进,在市
场上已经借由安全、环保、小巧等性能以及无化学残留等优势逐步
取代了较低功率的紫外线水银灯管。金鉴实验室通过以往的UV
LED杀菌测试案例总结发现品牌、灯珠灯具类型、波长、发光效率、照射距离、照射时间、
辐射强度、穿透性率、应用领域等是UV-LED
不同于紫外汞灯的消毒与灭菌鉴定实验结果的影响因素。在本文中,
im电竞列举三个实验说明其中几个因素的重要性,并建议
客户根据产品性能和应用领域的不同科学的设计实验条件,评估UV-LED紫外灯的
杀菌效果。

一、同一产品对不同菌种的杀菌效果对比
某客户委托金鉴实验室对UV LED灯具进行杀菌测试。金鉴工程师测试此款灯具中心
波长为275nm,在照射距离1m时其辐射强度为98μW/cm 2,垂直照射15min后对
比空白组评价对白色念珠菌、金黄色葡萄球菌及大肠杆菌的杀菌效果。本次试验中
试验结果显示同种UV LED虽然辐射强度相同,但对不同菌种的杀菌效果不同。

二、同一产品不同照射时间的效果对比
某客户委托金鉴实验室对UV LED灯珠进行不同条件的杀菌对比测试。金鉴工程师
测试送样款UV LED灯珠中心波长为280nm,距离培养基上方垂直照射30s、40s、
50s后评价其对大肠杆菌的杀菌效果。本次试验显示在相同照射距离下,UV LED
随照射时间的增加,杀菌效果明显增强,本款UVLED紫外线灯对大肠杆菌照射50s
后有较好的杀菌效果。测试效果如下所示:



三、同一产品不同照射距离的效果对比
某客户委托金鉴实验室对UV LED灯珠进行杀菌测试,金鉴工程师测试此款UV LED
灯珠中心波长为 275nm。距离培养基上方垂直5cm、7cm、10cm照射60S后评价
其对金黄色葡萄球菌的杀菌效果。本次试验中UV LED紫外线灯在相同的照射时间下,
随着距离的增加,杀菌效果明显降低;在距离5cm时对金黄色葡萄球菌有较好的
杀菌效果。测试效果如下所示:



相对于传统紫外线灯,金鉴实验室认为设计UVLED杀菌实验需考虑以下差异:
1. 波段:不同波段紫外线对于细菌,病毒的杀灭效果不同。传统用的紫外汞灯以
放电产生以波长为253.7nm为主的紫外辐射,但根据目前最新的研究结果,
在264纳米附近,紫外线的杀菌效果可能会更高。在深紫外UVC LED杀菌
消毒方面,标准化面临着一系列的挑战,如紫外汞灯杀菌主要在253.7nm,而UVC
LED波长主要分布在200-280nm,这为后续应用解决方案带来了一系列差异。
2. 紫外线剂量:杀菌需要足够的照射强度、足够的时间及合适的波段。紫外辐射强度
取决于紫外光源中有效光谱的发光强度、灯具的光输出角度(光束集中度)、灯具与
被辐射物体之间的距离等因素。一般来说,辐射强度越高效果越好
;光束越集中于被辐射物体表面杀菌效果越好;距离被辐射物体越近效果越好;
累积辐射时间即被照物体在紫外线灯具下的总辐射时间越长效果越好。
3. 发光效率:目前紫外LED在发光效率等方面还无法完全取代汞灯。UVA LED
技术已比较成熟,EQE可达到50-60%,针对UVA的产品未来更多的工作会聚
焦于应用系统层面的开发。UVB和UVC波段深紫外LED的外量子效率还比较低,
EQE普遍在10%以下,商业化产品基本在1%~3%。
4. 应用领域:紫外LED还具有小巧便携、环保安全、易于设计等优点,可以催生
出一些不同于传统汞灯的应用需求。比如目前已经出现的便携式的电子消毒产品、
电梯扶手杀菌机、扫地机器人等。这是传统紫外光源很难应用的地方。

5. 紫外线穿透性:UV LED对直接照射的物体表面具有良好的灭活效果,但穿透性
不强,对光线穿透不了的物体内部和被覆盖的部分,没有明显的效果,而传统紫外
线灯可利用产生的臭氧的弥散性弥补由于紫外线只沿直线传播、消毒有死角的缺点。
6. 杀菌差异:不同品牌、不同规格的紫外线灯杀菌差异性大,选购时要确认其光源
辐射波长、辐射强度、防护设计、工作要求等,选择合适的灯具。金鉴实验室作为
一家专门从事LED品质管理的第三方实验室,通过了检验检测机构资质认定(CMA)
、中国合格评定国家认可委员会实验室认可(CNAS)、ISO 9001质量管理体系等认证,
特向市场推出“UV LED紫外杀菌实验”的服务项目。根据品牌、灯珠灯
具类型、波长、发光效率、照射距离、照射时间、辐射强度、穿透性率、应用领域等
影响消毒与灭菌鉴定结果的因素,与客户共同设计实验方案,科学地评估UV-LED紫外灯
的杀菌效果。
其中优化测试方案:
1. 不同菌种对比测试
2. 不同照射距离杀菌效果对比测试
3. 不同照射时间杀菌效果对比测试
4. 不同辐射强度杀菌效果对比测试
5. 不同产品同样测试条件对比测试
......
测试菌种:金黄色葡萄球、大肠杆菌、铜绿假单胞菌、白色葡萄球菌、龟分枝杆菌脓
肿亚种、枯草杆菌黑色变种芽孢、白色念珠菌等。
注:金黄色葡萄球菌ATCC 6538作为细菌繁殖体中化脓性球菌的代表;
大肠杆菌8099作为细菌繁殖体中肠道菌的代表;
铜绿假单胞菌ATCC 15442作为医院感染中最常分离的细菌繁殖体的代表;
白色葡萄球菌8032作为空气中细菌的代表;
龟分枝杆菌脓肿亚种ATCC 93326作为人结核分枝杆菌的代表;
枯草杆菌黑色变种芽孢ATCC 9372作为细菌芽孢的代表;
白色念珠菌ATCC 10231作为致病性真菌的代表。
执行标准:《消毒技术规范》、《GB 28235-2011紫外线空气消毒器安全与卫生标准》
、《HJ2522-2012环境保护产品技术要求紫外线消毒装置》、
《WST367-2012医疗机构消毒技术规范》及金鉴实验室企业标准。
附录:
一、深紫外UV LED杀菌消毒优势:
1. 高效率杀菌:对细菌、病菌的杀菌灭活一般是几秒内完成,几乎是瞬时发生。
2. 杀菌广谱性:对几乎所有细菌病毒都能高效率杀灭。
3. 无二次污染:没有其他化学污染物产生。
点击查看:深紫外光对常见细菌病毒的杀菌效率
二、紫外波段分类
根据波长划分紫外波段:
UVA:315-400nm(近紫外NUV365-400nm),应用包括固化、光催化净化、防伪等领域。
UVB:280-315nm,应用包括光健 康/医疗、植物生长光照调节等。
UVC:200-280nm(solar blind——“日盲”紫外线),应用于如水、空气等的杀菌消毒。

三、紫外线消毒原理
紫外线消毒技术是基于现代防疫学、医学和光动力学的研究基础,利用专门设计的高
效率、高强度和长寿命的UVC波段
紫外光灯具来实现的。紫外线通过对微生物(细菌、病毒、芽孢等病原体)的辐射损伤
和破坏核酸的功能,从而使微生物
致死,达到消毒和杀菌的目的,灭活效果取决于紫外辐射剂量。
微生物结构与紫外线灭活机理:

四、第一、二类消毒产品
国家卫生和计划生育委员会(卫生计生委)出台相应政策,要求第一、二类消毒产品首
次上市前需要自行或委托第三方进行
卫生安全评价,评价合格的消毒产品方可上市销售。即上市前需委托第三方检测评价机
构进行卫生安全评价,出具专业检测
报告,政府备案,产品方可上市销售。
第一类消毒产品是指具有较高风险,需要严格管理以保证安全、有效的消毒产品。包括
用于医疗器械的高水平消毒剂和消毒
器械、杀菌剂和杀菌器械,皮肤黏膜消毒剂,生物指示物、杀菌效果化学指示物。
第二类消毒产品是指具有中度风险,需要加强管理以保证安全、有效的消毒产品,包括
除第一类产品外的消毒剂、消毒器械、
化学指示物,以及带有杀菌标识的杀菌物品包装物、抗(抑)菌制剂。

在追求个性化与智能化照明的今天,传统的单色光源已无法满足市场日益增长的创意需求。im电竞光电,作为领先的LED封装制造商,隆重推出2835幻彩LED灯珠,以其卓越的性能和灵活的智能控制能力,成为点亮未来视觉盛宴的核心引擎。无论您是工程师、设计师还是制造商,这款产品都将为您的项目注入无限活力。一、产品核心优势:为何...